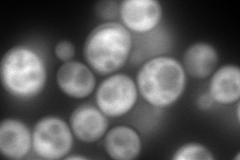
YBR196C
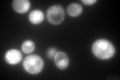
YBR196C

View description
Glycolytic enzyme phosphoglucose isomerase, catalyzes the interconversion of glucose-6-phosphate and fructose-6-phosphate; required for cell cycle progression and completion of the gluconeogenic events of sporulation
Localization:
Intensity:
Fold change:
Significance:
-
C’ GFP library in SD

cytosol856.73 -
N' NOP1pr-GFP in SD
cytosol379.612 -
N' TEF2pr-mCherry in SD

cytosol451.859 -
N' NATIVEpr-GFP in SD

cytosol20.2132 -
N' TEF2pr-VC and Cyto-VN in SD

cytosol93.5661 -
C’ GFP library in SD+DTT

cytosol1258.21.46Yes -
C’ GFP library in SD+H2O2

cytosol964.861.12No -
C’ GFP library in Starvation Media
cytosol963.731.12No -
C’ GFP library on the background of Pup2-DaMP

N/A -
C’ GFP library on the background of CCT mutant

N/A0N/AYes
